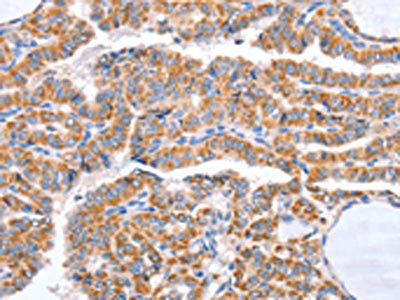

B3GAT1 Antibody
-
中文名稱:B3GAT1兔多克隆抗體
-
貨號:CSB-PA280651
-
規格:¥1100
-
圖片:
-
The image on the left is immunohistochemistry of paraffin-embedded Human liver cancer tissue using CSB-PA280651(B3GAT1 Antibody) at dilution 1/50, on the right is treated with synthetic peptide. (Original magnification: ×200)
-
The image on the left is immunohistochemistry of paraffin-embedded Human thyroid cancer tissue using CSB-PA280651(B3GAT1 Antibody) at dilution 1/50, on the right is treated with synthetic peptide. (Original magnification: ×200)
-
Gel: 10%SDS-PAGE, Lysate: 40 μg, Lane: Human chromaffin cell tumor tissue, Primary antibody: CSB-PA280651(B3GAT1 Antibody) at dilution 1/600, Secondary antibody: Goat anti rabbit IgG at 1/8000 dilution, Exposure time: 3 minutes
-
-
其他:
產品詳情
-
Uniprot No.:
-
基因名:B3GAT1
-
別名:3-glucuronyltransferase 1 antibody; 3-glucuronyltransferase antibody; B3GA1_HUMAN antibody; B3gat1 antibody; Beta 1 3 glucuronyltransferase 1 antibody; Beta-1 antibody; Beta-1,3-glucuronyltransferase 1 antibody; CD 57 antibody; CD57 antibody; CD57 antigen antibody; Galactosylgalactosylxylosylprotein 3 beta glucuronosyltransferase 1 antibody; Galactosylgalactosylxylosylprotein 3-beta-glucuronosyltransferase 1 antibody; GlcAT P antibody; GlcAT-P antibody; GLCATP antibody; GlcUAT P antibody; GlcUAT-P antibody; GlcUATP antibody; Glucuronosyltransferase P antibody; HNK 1 antibody; HNK1 antibody; LEU 7 antibody; LEU7 antibody; LEU7 antigen antibody; NK 1 antibody; NK1 antibody; UDP GlcUA glycoprotein beta 1 3 glucuronyltransferase antibody; UDP-GlcUA:glycoprotein beta-1 antibody
-
宿主:Rabbit
-
反應種屬:Human,Mouse,Rat
-
免疫原:Synthetic peptide of Human B3GAT1
-
免疫原種屬:Homo sapiens (Human)
-
標記方式:Non-conjugated
-
抗體亞型:IgG
-
純化方式:Antigen affinity purification
-
濃度:It differs from different batches. Please contact us to confirm it.
-
保存緩沖液:-20°C, pH7.4 PBS, 0.05% NaN3, 40% Glycerol
-
產品提供形式:Liquid
-
應用范圍:ELISA,WB,IHC
-
推薦稀釋比:
Application Recommended Dilution ELISA 1:1000-1:2000 WB 1:200-1:1000 IHC 1:50-1:200 -
Protocols:
-
儲存條件:Upon receipt, store at -20°C or -80°C. Avoid repeated freeze.
-
貨期:Basically, we can dispatch the products out in 1-3 working days after receiving your orders. Delivery time maybe differs from different purchasing way or location, please kindly consult your local distributors for specific delivery time.
-
用途:For Research Use Only. Not for use in diagnostic or therapeutic procedures.
相關產品
靶點詳情
-
功能:Involved in the biosynthesis of L2/HNK-1 carbohydrate epitope on glycoproteins. Can also play a role in glycosaminoglycan biosynthesis. Substrates include asialo-orosomucoid (ASOR), asialo-fetuin, and asialo-neural cell adhesion molecule. Requires sphingomyelin for activity: stearoyl-sphingomyelin was the most effective, followed by palmitoyl-sphingomyelin and lignoceroyl-sphingomyelin. Activity was demonstrated only for sphingomyelin with a saturated fatty acid and not for that with an unsaturated fatty acid, regardless of the length of the acyl group.
-
基因功能參考文獻:
- Cellular levels of HNK-1 carrier glycoforms are decreased in the brain of Alzheimer's disease subjects. PMID: 26738850
- CD4(+) T cells that coexpress CD57 and CD154, which are exclusively present in cytomegalovirus-positive individuals. PMID: 27566833
- greater HIV RNA transcription was associated with lower CD57 expression on CD8 T cells. Although causality cannot be inferred from this retrospective study, these results suggest that asymptomatic CMV replication and residual cellular HIV transcription may contribute to persistent immune dysregulation during suppressive ART. PMID: 26818740
- TRAF4 expression is higher in mastocytosis patients with food hypersensitivity in their medical history, while B3GAT1 expression is lower in mastocytosis patients with insect venom allergy in history PMID: 27086366
- analysis of natural killer cell markers in renal transplantation that have roles in acute rejection reveals that CD56 and CD57 are increased in the interstitial compartment in donor-specific antibody (DSA)-negative biopsies from patients with acute antibody-mediated rejection without C4d, and CD16 is increased in the glomerular compartment in DSA-positive biopsies PMID: 26615051
- Case Report: chronic lymphocytic leukemia with aberrant CD56 and CD57 expression. PMID: 26013700
- Among CD8+ T-lymphocytes, CD28+CD57+ cells represent a subset with some senescent features that are distinct from the CD28-CD57+ cells. PMID: 26277688
- analysis of CD57 in prostate neoplasms and benign prostatic tissue PMID: 24977150
- The frequency of CD57-expressing antigen specific CD4+ T cells was higher in active compared to latent tuberculosis. PMID: 25931385
- glioblastoma stem cells are killed by CD133-specific CAR T cells but induce the T cell aging marker CD57 PMID: 25426558
- polyfunctional CD57+ cell expansion has a role in CD8+ T cell response to Staphylococcal Enterotoxin B during CMV latent infection PMID: 24533103
- Our results suggest that an increase in the population of CD57(+) T-cells is a potent prognostic marker and may also influence the systemic immunity of patients with OSCC. PMID: 25275081
- Abnormally low proportions of CD28(-)CD8(+) T cells expressing CD57 predict increased mortality during treated HIV infection and may be reversed with early ART initiation. PMID: 24585893
- NKG2C(hi)CD57+ NK cells respond specifically to acute infection with cytomegalovirus and not Epstein-Barr virus. PMID: 24740502
- CD56dim CD57int NK cells represent an intermediate functional phenotype in response to vaccine-induced and receptor-mediated stimuli. PMID: 24843874
- T cells in unaffected skin from psoriasis patients exhibit a phenotype compatible with replicative inability. As they have a lower replicative capacity, CD57+ T cells are less frequent in lesional tissue due to the high cellular turnover. PMID: 23468834
- NKG2Chi CD57hi natural killer cells are highly responsive to human cytomegalovirus-infected macrophages only in the presence of HCMV-specific antibodies, whereas they are functionally poor effectors of natural cytotoxicity. PMID: 23637420
- Analysis identified CD57(bright) expression as a reliable phenotype of granule marker-containing cytotoxic T-lymphocytes. PMID: 23287865
- Strong expression of CD57 correlates with aggressive attributes of U-NB1 and SK-N-BE(2)-C neuroblastoma cells and is linked with undifferentiated neuroblastoma cells in patients. PMID: 22900004
- HIV infected subjects had higher percentage of T cell subsets expressing CD57. PMID: 22310831
- CD57+ cells may be involved in chronic obstructive pulmonary disease pathogenesis, especially in the most severe stages of the disease. PMID: 22127595
- 33 directly measured and 13 derived glycosylation traits in 3533 individuals were identified and three novel gene association (MGAT5, B3GAT1 and SLC9A9) were identified using an additional European cohort. PMID: 21908519
- an increase in CD4+CD57+ T cells controls the capability of PB to produce the anti-tumor cytokine IFN-gamma and PB-IFN-gamma production is impaired with HCC tumor progression PMID: 21491089
- The donor HNK1 haplotype is associated with better clinical outcome among recipients, with standard-risk disease, of bone marrow transplants from HLA-matched unrelated donors. PMID: 19794085
- The density of CD57+ cells within lymphoid follicles of chronic obstructive pulmonary disease patients was significantly increased compared to that of nonsmokers and smokers without chronic obstructive pulmonary disease. PMID: 20525712
- Lung biopsies from idiopathic pulmonary fibrosis showed upregulation of GlcAT-I, a rate-limiting enzyme in GAG synthesis. PMID: 21056957
- assessed the transcriptional, phenotypic, and functional differences between CD57(+) and CD57(-) NK cells within the CD56(dim) mature NK subset PMID: 20733159
- CD56(dim) NK cells continue to differentiate. During this process, they lose expression of NKG2A, sequentially acquire inhibitory killer cell inhibitory immunoglobulin-like receptors and CD57. PMID: 20696944
- Protein-bound polysaccharide K improves overall survival of stage III gastric cancer patients partly by inhibiting CD57(+) T cells. PMID: 20229169
- substrate specificity toward UDP-glucuronic acid determined by two crucial histidine and arginine residues PMID: 11986319
- Expression of CD57 defines replicative senescence and HIV antigen-induced apoptotic death of CD8+ T cells, and CD57 may be involved in apoptosis and lack of proliferation. PMID: 12433688
- differences in CgA and CD57 expression in human neuroendocrine tumors are related to the degree of differentiation of the neoplasms and probably reflect the degree of maturation (functional state) of neuroendocrine granules within the neoplastic cells. PMID: 12687271
- Polymorphic or other variation of the 11q telomere may affect the activity of B3GAT1 and be a risk factor for schizophrenia and related psychoses in the general population. PMID: 12874601
- CD57 has a role in antitumor immunity which is impaired in gastric cancer PMID: 12883721
- GlcAT-P is an enzyme critical in the biosynthesis of the carbohydrate epitope HNK-1 PMID: 14993226
- first pediatric case describing coexpression of CD57 on B-lineage acute lymphoblastic leukemia PMID: 15626024
- CD8-positive T cells expressing CD57, a marker of replicative senescence, also express killer cell lectin-like receptor G1 (KLRG1); however, a population of CD57-negative KLRG1+ cells is also identified. This population may represent a "memory" phenotype. PMID: 15879103
- It was found that collagen type IX and HNK-1 epitope were present in tears, the amount of the former being increased 2.7 times compared to normal. PMID: 16257185
- study identifies GlcAT-I as a target of calcium-dependent signaling pathway and evidences the critical role of Sp1 transcription factor in the activation of GlcAT-I expression PMID: 16807373
- CD8+CD57+ T cells are a subset of effector cells that could be helpful to evaluate the cell-mediated immune response to Mycobacterium tuberculosis PMID: 17035093
- data suggest that the expression of CD30 and CD57 cell markers on T cells could reflect circulating effector T cell early activation in the allergic airway disease. PMID: 18201430
- ability of CD8hi CD57+ T cells to further differentiate is highlighted by a distinct cytokine profile late after activation that includes the unexpected release of high levels of interleukin PMID: 18383036
- Overexpression of HNK-1 is associated with metastasis in melanoma. PMID: 18802400
- CD57 was linked to higher apoptosis resistance in CD8(+) T cells in HIV infection. PMID: 19564339
顯示更多
收起更多
-
亞細胞定位:[Isoform 1]: Golgi apparatus membrane; Single-pass type II membrane protein. Secreted.; [Isoform 2]: Golgi apparatus membrane; Single-pass type II membrane protein. Endoplasmic reticulum membrane. Secreted.
-
蛋白家族:Glycosyltransferase 43 family
-
組織特異性:Mainly expressed in the brain.
-
數據庫鏈接:
Most popular with customers
-
-
YWHAB Recombinant Monoclonal Antibody
Applications: ELISA, WB, IHC, IF, FC
Species Reactivity: Human, Mouse, Rat
-
Phospho-YAP1 (S127) Recombinant Monoclonal Antibody
Applications: ELISA, WB, IHC
Species Reactivity: Human
-
-
-
-
-